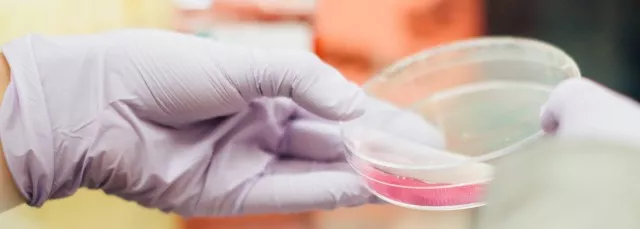

香港中文大学(深圳)理工学院本科专业介绍
发布时间:2019-05-08 16:05:20 阅读量:
综合考虑了国际学科发展趋势、结合珠三角、全国及全球对理工人才的需求,香港中文大学(深圳)理工学院开设了统计学、数学与应用数学、生物信息学(理工学院、生命与健康科学学院联合招生;本专业属生命与健康科学学院)、生物医学工程、计算机科学与技术、电子信息工程、新能源科学与工程、金融工程(理工学院与经管学院联合招生)。

统计学 Statistics
统计学是研究数据的收集、分析和诠释,从而获取信息和支持决策的一门学科。本专业学生将会学到统计理论和计算技术,掌握从数据中获得有效信息的技能,以应对大数据的挑战。本专业将根据金融、商务、工业、医药及政府决策等方面对数据分析的需求,帮助学生认识统计学在各领域的广泛应用,扩宽学生的知识结构,培养其解决各类实际问题的能力。
本专业提供三个专修方向给学生修读:
★ 数据科学 (Data Science):利用先进的计算机技术,结合统计理论,挖掘数据中的“知识”。
★ 金融统计(Financial Statistics):收集各项金融业务活动信息,分析金融活动的趋势,支持金融投资决策和风险控制。
★ 统计科学(Statistical Science):从数学角度研究统计学,支持应用统计学的理论发展。
毕业生可继续深造,攻读硕士、博士学位;也可进入政府、银行、保险公司、证券公司等金融部门,或者进入咨询公司、工商企业的市场研究部门、质量检测部门等。

数学及应用数学 Mathematics and Applied Mathematics
数学在人类历史发展和社会生活中发挥着不可替代的作用,也是学习和研究现代科学技术必不可少的基本工具;进入信息化时代,在大数据筛分、智慧城市、金融分析、风险管理、经济调控等各方面,这门历久弥新的学科扮演着愈发重要的角色。
本专业提供三个专修方向给学生修读:
★ 理论数学 (Pure Mathematics):研究数学本身,分有研究空间形式的几何类、研究离散系统的代数类、研究连续现象的分析类。
★ 应用数学(Applied Mathematics):学习数学的基础理论和基本方法,运用数学模型、计算机和数学软件解决实际问题。
★ 金融数学(Financial Mathematics):利用数学工具研究金融,进行数学建模、理论分析、数值计算等定量分析。
本专业将结合深圳IT、金融、物流中心的优势,拓展学生的行业视野,提供职业规划辅导,构建在业界实践的平台。毕业生将在金融、物流、IT、电子等有着广泛的职业选择;部分毕业生将会在海内外著名大学继续攻读硕士、博士学位。

生物信息学* Bioinformatics
生物信息学应用计算机科学、信息科学、统计和信息技术来解决生命科学和医学领域的复杂问题。随着高通量技术的发展,产生了大量的生物定量数据;信息技术开始被广泛用来收集、传输和管理这些逐年激增的数据,然后用数学、物理和统计方法来分析。生物信息学在一些前沿领域起到了关键作用,比如基因组学、蛋白组学、蛋白质工程、代谢工程、药物开发、疫苗设计、诊断试剂等。
本专业兼顾生物学基础以及计算机和生物信息学理论知识和实践能力的培养,重点培养学生的创新创造能力以及独立思考的能力。毕业生将成为海内外著名高校相关学科方向争先吸引的研究生培养对象,同时也能参与研究院校、药企、医院等相关部门的研究和工作。
*理工学院、生命与健康科学学院联合招生;本专业属生命与健康科学学院
生物医学工程 Biomedical Science and Engineering
生物医学工程关注改善人类健康所遇到的核心问题——透过创新应用科学、工程和技术解决生物学和医学问题理解复杂的生物系统及设计相应的治疗技术。重点领域包括系统生物、细胞及组织工程、神经工程、计算生物、以及传感器、测试设备和微/纳米技术。
学生于首两年修读一般的理工科目及生物医学工程的基础科目;在第三年学习日常与生物医学工程相关的常见核心问题;在第四年集中学习生物医学工程的应用领域,为学生提供直接于业界实践的知识或进一步深造的基础。生物医学工程专业将怀着服务社会及推进保健科技的抱负,培育出新一代生物医学家及工程师。

计算机科学与技术 Computer Science and Engineering
随着计算机融入日常工作和生活的方方面面,作为信息化核心的计算机科学与技术已成为最重要的学科之一:涵盖面广、应用面宽、应用层次跨度大。本专业学生将系统、扎实地掌握基础理论和专业知识,以及计算机及相关学科领域最新发展。
本专业注重培养学生的创新与实践能力,紧密结合珠三角蓬勃发展的信息技术产业,学习技术成果在商业产品中的应用。多位国际著名学者应邀来校讲学、举办研讨会,提供业界实践和海外交流机会,拓展学生的全球视野。毕业生将可寻找在著名高等院校进一步深造的机会,亦可在信息产业、金融业、制造业等领域从事科学研究、产品开发与应用。

电子信息工程 Electronic Information Engineering
互联网经济的蓬勃发展,对开发更便捷、安全和可靠的新产品与服务(网上银行、在线交易等)的需求日益显著。本专业的学生将掌握在电子科学、信息科学和计算机领域内宽厚的理论基础、专业知识和实验能力,并能够参与新产品、新技术、新工艺的创意设计和研发。
该专业不仅注重学生的专业基础,也强调学生国际视野的拓展。我们利用深圳作为中国通信及电子信息产业最重要基地的优势,增强学生掌握行业动态的能力,提供机会参与业界交流和实践,提升学生的创新和实践能力。毕业生所接受的全面教育,将可令其既可在国内外学术领域深造学习,也可在电子、信息、金融、制造等产业研发及政府机构管理中就业发展。

新能源科学与工程 New Energy Science and Engineering
本专业旨在本科教育的层面回应新能源发展的诉求,培育具备跨学科知识与技能的专业人才。学习范畴包括:
★ 太阳能转换
★ 氢能的生产和储存,及燃料电池
★ 储能(电池、超级电容器)
★ 新能源发电(热电等)
★ 智能电网
★ 能源效率与节能
学生将接受严格的传统学科(如化学、物理、材料科学等)的训练,也将学习有关学科新的发展(如生物分子工程、光化学、电化学等)。我们将携手珠三角地区的新能源公司,及时传递行业动态,拓展学生的行业视野,提供在工业界实践的机会。毕业生可寻找国内外一流院校继续深造学习的机会,也可进入新能源的生产、运营和相关装备建造等工业领域就业。
金融工程* Financial Engineering
本课程的毕业生具有较强的计量及分析能力,有成为未来金融行业领袖的潜质,并能满足金融行业对人才的需求。毕业生将具备全面的金融建模与预测能力,因此能胜任对计量及分析能力要求极高的职位与工作,例如估值、投资组合分析、资产配置、信用分析、风险模型,以及结构性融资。本课程还 为毕业生在投资银行、商业与企业银行,以及金融服务单位中的职业发展打下良好基础。
本课程将是珠江三角洲地区唯一的计量金融和金融科技课程,拥有最先进的设施,包括全国最好的金融交易实验 室,并借鉴香港中文大学计量金融课程的成功经验,该课程在过去十年培养了大量广受主要国际投资 银行和金融机构欢迎的毕业生。
*理工学院与经管学院联合招生
欢迎2019高考生及家长扫码咨询,了解港校面试最新动态
咨询微信:gangdams
优朗港校面试官方微信公众号:gangdamianshi

400-800-8273